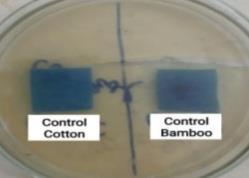
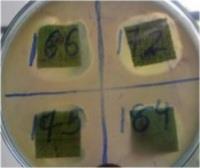
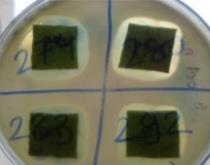
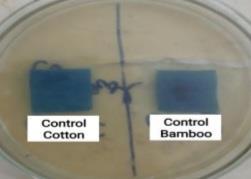
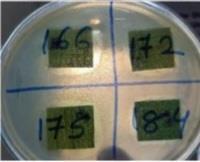

International Research Journal of Engineering and Technology (IRJET) e-ISSN: 2395-0056
Volume: 11 Issue: 04 | Apr 2024 www.irjet.net p-ISSN: 2395-0072
![]()

International Research Journal of Engineering and Technology (IRJET) e-ISSN: 2395-0056
Volume: 11 Issue: 04 | Apr 2024 www.irjet.net p-ISSN: 2395-0072
Jinal K. Rohit 1 , Dr. Jayendra N. Shah 2
1M.Tech Scholar, Department of Textile Chemistry, Maharaja Sayajirao University of Baroda, Gujarat, India
2Associate Professor, Department of Textile Chemistry, Maharaja Sayajirao University of Baroda, Gujarat, India
The Comprehensive focus on plant Based extract in textile coating as textile finish. This study deals with extractionofNeem(Azadirachtaindica)leavesusingwaterandmethanol.TheNeem(Azadirachtaindica)have been applied to cotton and as well as on Bamboo fabric in presence and absence of free formaldehyde crosslinkingagent(Glyoxal) usingPad-Dry-Curemethod.Antimicrobial properties of treated fabric havebeen improved which make it more important and inevitable finish for Garments. The Azadirachta indica treated fabric exhibited antimicrobial activity against both Gram negative and Gram Positive Bacteria. The Treated cottonandBamboofabrichaveshownanexcellentantimicrobialactivity.Thesamplewereexaminedofcotton and Bamboo including, Colour Strength Value and also the treated fabric show very good results for UV protection. The novel feature of this study was the use of SEM and FT-IR spectroscopy to identify the major chemicalgroupsintheextractaswellasitsattachmentoncottonandbamboo.
Keywords: Azdirachta indica leaves, Ecofriendly antimicrobial finishing, Herbal extract, cotton and Bamboo fabric.
Azadirachta indica commonly known as “Neem” belongs to Meliaceae botanical family and being abundantly available in nature. The principal constituents of these leave include protein (7.1%), carbohydrates (22.9%), minerals, calcium, phosphorus,vitaminC,caroteneetc.Anextractfromtheleavescanbepreparedasanalcoholictinctureorasteaandthis alcoholextracthasadarkgreencolour.Thechemicalcompositionoftheextractcontainsglutamicacid,tyrosine,aspartic acid,alanine,praline,glutamineandcystinelikeaminoacids,andseveralfattyacids(dodecanoic,tetradecanoic,elcosanic, etc.). But physically the Azadirachta indica leaves have a pleasant odor and plant pigments like chlorophyll mainly responsibleforgreencolour[1-3] TheAzadirachtaindicaextractisreportedlyofficiousagainstavariety ofskindiseases, septic sources and infected burns. The most important quality of these compounds is that they are less toxic to warm bloodedanimalslikehuman.Thus,consideringitslesstoxicityand effectivenessagainstmicroorganism,itisexpectedto beoneofthesafestandmosteffectivecolourantcumantimicrobialagentfortextile[4-6]
Table 1: Various compounds from various parts of Neem plant and their biological activity[7]
Sr.No Compounds Source BiologicalActivity
1 Nimbin Seedoil SpermicidalAntifungal,Antibacterial
2 Nimbidine SeedOil Antipyretic,Antiarthritic,
3 Azadirachtin SeedOil Antimalarial
4 CyclicTetra-sulphide Leaf Antifungal
5 Mahmoodin SeedOil Antibacterial
6 Margolone Bark Antibacterial
7 GallicacidandCatechin Bark Anti-inflammatory
8 PolysaccrideG1A,G1B Bark Antitumour

International Research Journal of Engineering and Technology (IRJET) e-ISSN: 2395-0056
Volume: 11 Issue: 04 | Apr 2024 www.irjet.net
p-ISSN: 2395-0072
Inrecentyears,thegrowingdemandforherbalproductshasledtotheideaofdevelopinghealthcaretextileproducts.The present examination aims at developing an eco-friendly antibacterial finishing agents from plant extracts. Some plants were identified, selective and screened for their antibacterial activities. Their extracts were applied to cotton fabric and bamboo fabric. Herbal extracts from chamomile leaf, green tea, and sage were selected for this study. The durability of finished cotton to several washing cycles have been studied. As known, herbal extracts shown a good antibacterial propertybutthispropertywasdecreasedafterwashing[8].
The presentwork focused onpreparedandevaluatetheextractfromAzadirachta indica,asnatural antimicrobial textile finishes. These extracts included active ingredients they are rich and contribute to controlling a variety of different diseases, -infections and allergies- but only few studies have been explored for their antimicrobial activity on textile material. This research discusses the application of different plant extract herbs on the cotton fabric in absence or presence of eco-friendly crosslinking agent (glyoxal) to help fixed it on the fabric, which in turn increase durability of treated cotton fabric to the desired properties, via herbs treatment. Experimental Material The desized, scoured and bleached cotton fabric and bamboo fabric. The fabric was purified by scouring at 100 °C for 60 min. using a solution containingNa2CO3(2g/l,wettingagent,1%),thenthoroughlywashedwithwateranddriedatambientconditions.Glyoxal, AluminuimSulphate.
2.1 Material
Thedesized,scouredandbleachedcottonfabricandpurchasedfromlocalmarketwereusedforthestudy.Thefabricwas purified by scouring at 100 0C for 60 min. using a solution containing Na2CO3 (2g/l, wetting agent, 1%), to remove dust particlesandfinishingchemicals,thenallthefabricwereneutralized,thoroughlywashedwithwateranddriedatambient conditions
2.2 Methods and procedures
2.2.1 Extraction of Azadirachta indica
NeemleavesFirstlyCollectedformtheplantandwashedwithwater.Theleavesweredriedat60-80 0Cforshorttimein laboratoryoven,sothatthevolatilecontentsarenotlost.DriedLeaveswereconvertedtofinepowerbygrinding.
TwoextractionTechniqueswereusedtoextractfromtheNeem(Azadirachtaindica)Powder.
1. Water Extraction: The10gmdriedneemwereSoakinginrequiredvolumeof100mlwaterforovernight.Thismixture isobtainedBrowncolouredsolutionareshowninfigure 1(a)andfilteredthroughwattmamfilterpaperno.1.finally,the total volume of extract was increased to 100ml with distilled water. This solution was used as stock solution of 10:100 strength.
2. Methanolic Extraction: Inthecaseofmethanolicextraction10gmofobtainedpowderofdriedNeemwasextractedin 100mlofmethanol.Thepowdersoakinginmethanolwasovernight,thismixtureisobtainedgreencolouredsolutionare showninfigure1(b)theextractwasfilteredthroughwattmenfilterpaperno.1.Thisextractwasusedasstocksolutionof 10:100strength.

International Research Journal of Engineering and Technology (IRJET) e-ISSN:
Volume: 11 Issue: 04 | Apr 2024 www.irjet.net p-ISSN: 2395-0072

(a) Water Extraction (b) Methanolic Extraction
Figure 1: Neem Extraction Through Obtained Coloured
2.3 Cotton and Bamboo Fabric Treatment with Azadirachta indica
The cotton fabric was treated with the product of the two extract methods (aqueous or methanol extract method). This treatment was done in absence or presence of eco-friendly crosslinking agent. Firstly, the cotton fabric was treated with herbal extract bydipmethod.Thefabric wasimmersed inthe two extractherbsfor 30minanddried.Thenthe finished cotton fabric was subjected for the antimicrobial assessment. Secondly, the cotton fabric was treated with the two previousherbalextractinpresenceofecofriendlycrosslinkingagentasfollow:2%ofherbalextractwasmixedwith6%of glyoxalascrosslinkingagentand4%aluminumsulphate Al2(SO4)3 wasaddedasacatalyst.Cottonfabricwaspaddeddip andnipinthefinishingformulaandthenthetreatedfabricwasdriedat80°Cfor5min.andcuredat120°Cfor3min
Pad-dry-cure method: It is the most common method, before extrusion synthetic fibers the antimicrobial agent is incorporatedinit.Thesimplestandoldestmethodappliedbythepad-dry-curemethodisthedirectapplicationbutitisn’t durable.
Cross-linking:Usageofcross-linkerstocreatecovalentintermolecularbridgesbetweenpolymerchains.
2.3.1 Optimization of bath pH
InordertooptimizepHofthebath,Finishingwasperformedinabsencewith10%(owf)finishingagentconcentrationby exhaust technique. glyoxal as crosslinking agent and aluminum sulphate (Al2 so4 )3 was added as a catalyst. Fixation was carried out in laboratory constant temperature shaking water bath at 98±2 0C for 45 min. The final result in terms of highercolourstrengthvaluewasselectedasoptimizedpHofliquor.
2.3.2 Optimum temperature
Tooptimizethetemperatureforfinishingbath,experimentswereconductedatdifferenttemperaturerangingfromroom temperature to boil i.e. 40 (R.T.), 60, and 80±2 °C At optimized pH. The dyebath contains 10 % (owf) extract and with liquorratioof50:1.
2.3.3 Optimum time
Inordertooptimizetimefordyeing, threebathswithoptimizedpHandtemperaturewithsameliquorratioof50:1were prepared. The temperature of these baths was raised to optimized temperature, and kept for fixation for 30, 45, and 60 minutesrespectively.
2.2.3 Washing cycle procedure
Theantibacterialactivityofthefinishedfabricwasevaluatedaftersubjectedtoseveralwashedcycles.Thefinishedfabrics werewashedusingnon-ionicdetergent2%owfat40 0 C.keepingthematerialtoliquorratioat1:50followedbyrinsing washinganddrying.
2.2.4 Characterization of treated fabric
Evaluationof DyedSamples.Thedyedsampleswereassessedfor��∗��∗��∗colourcoordinatesandK/Svalues(illuminate D65/100 observer) on spectra scan 5100 (RT) spectrophotometer (Premier Colour scan Instrument). The antibacterial

International Research Journal of Engineering and Technology (IRJET) e-ISSN: 2395-0056
Volume: 11 Issue: 04 | Apr 2024 www.irjet.net p-ISSN: 2395-0072
activity was checked against both Gram positive bacteria and Gram negative bacteria according to Test Methods as per AATCC - 147 for E.Coli and Bacillus subtilis (Agar well diffusion method). Ultraviolet protection factor (UPF) optimum treatedanduntreatedsamplewasanalysedusingUV-2000Finstrumentmakelabspherewereusedforthispurposeinthe UV wavelength range (290 to 400nm). The surface morphology of treated fabrics was established by using scanning electronmicroscope(SEM).IRspectraofuntreatedandtreatedfabricsampleswerestructuralanalysisinShimadzuFTIR 8300infraredspectrometer.
TheCottonandBamboofabricsamplewerepreparedfordyeingthendyedwithReactivedye(CoracionBlue HERD)and then Finished with Natural Bioactive Agent choice. The dyed sample were subjected to finishing with natural bioactive agent Finishing Choice for work Neem (Azadirachta Indica). This finished samples were analysed to study the antimicrobial and UV-Protection Functionality. The results include the evaluation of various of functional properties including antimicrobial and UV-Protection with the help of various physical, analytical and structural analysis of the sampleobtainedusingvariousvariables
3.1 Effect of Natural Bioactive Finishing Techniques on Colour Strength Value (K/S Values)
TheCottonandBamboobeingaCellulosicmaterialcanbedyedwithCoracionBlueHERDReactivedyethenfinishingwith natural finishing agent such as Neem (Azadirachta indica). The control sample is considered dyed fabric is considered before finishing. In the present study the cotton and bamboo on functional finishing through the colour strength and colour co-ordinate values is evaluated and mentioned in Tables 2. The kubelka and Munk derived an equation as follow K/S=(1-R)2/2R WhereKisabsorptioncoefficient,Sis ScatteringCoefficientandR isReflectanceofsample.The colour strengthmeasurementofcolourstrengthsamplewasevaluatedbyalightreflectancetechniqueusingSpectrophotometer with computer colour matching system; Spectra Scan 5100 (RT) (Premier colour scan instrument), India. The colour coordinate in value (Lab value), ‘L*’ represents colour shade i.e., lower the value of ‘L*’, darker the sample and vice versa. Tone of any colour is specified by two components, namely, ‘a*’ and ‘b*’. Negative values of ‘a*’ indicates that tone is on greenersideandpositivevalueswillindicatestoneonredderside.Whereasnegativevaluesofsymbol‘b*’indicatesbluer toneandpositivevaluesindicateyellowertone.
Table 2: Colour strength (K/S Values) and Colour co-ordinates of Neem (Azadirachta Indica) bioactive finishing on Cotton and bamboo
N.W- NeemwaterExtractionTreatedsample, N.M-NeemMethanolicExtractiontreatedsample Hereisdescribed toparametersoftheConcentration,Time,Temperatureinnumbers.Were, 1- 20%Conc.,60min,80 0C, 2- 30% Conc.,30min,80 0C, 3- 30%Conc.,60min,R.T(35-40 0C), 4- 30%Conc.,60min,80 0C.
ObservationofabovetableinclearlyindicatethatcottonandBamboofabricsampleofColour StrengthvalueandColour co-ordinatesvalueofN.WTreatmentinhigherisN.W4at30%Conc.,60min,80 0C.andLowercolourstrengthatN.W2at

International Research Journal of Engineering and Technology (IRJET) e-ISSN: 2395-0056
Volume: 11 Issue: 04 | Apr 2024 www.irjet.net p-ISSN: 2395-0072
30%Conc.,30min,80 0Conbothtextilematerial. ThecontroldyedfabrichascolourstrengthvalueishigherthanN.W1, N.W2,N.W3andN.W4onbothCottonandBamboofabric.andN.Mtreatedcottonandbamboohasresultsareshownin table18inhighervalueisN.M.4at30%Conc.,60min, 80 0C.andloweratN.M1at20%Conc.,60min,80C.TheNeem methanolicextracthascolourstrengthvalueoncottonaswellasbamboofabricsampleofN.M1,N.M2,N.M3,andN.M 4ishigherthanthecontroldyedtextilematerial.
Applicationoffunctionfinishingoncottonandbamboobynaturalbioactiveagentispresentinwaterassinglemolecules (ionized) as well as clusters of many molecules (aggregates). Aggregates are too large to enter the interior of fibres at a giventemperature.Raisingthetemperatureleadstothebreakingdownofaggregates.So,thenumberofsinglemolecules existinginthesolutionincreases.Whena singlemoleculedeliberateformtheaggregates,whichare,inturn,takenupby thefabric,resultinginacompletecolourstrength[9].
The control sample is considered dyed fabric is considered before finishing. The sample after finishing with under differentconditiondescribedisearlier.ThecottonandbamboofabricsamplewereFinishingwithNaturalBioactiveagent areNeem(Azadirachta Indica).Theantibacterial activityoftreatedfabricwasevaluatedquantitativelybymeasuringthe numberofcoloniesofBacillussubtilis(Gram-positive)andE.coli(Gram-negative)asperthetestmethoddiscussedinthe experimental section. Qualitative assessment of the antibacterial activity of the treated cotton and bamboo fabrics were carriedoutbyParallelStreakMethod(AATCC147).
Thezoneofinhibitionsobtainedinthedifferenttreatmentswasobservedandillustrated inTable3.Theuntreatedsample of cotton and bamboo has no antimicrobial activity was found. Therefore, antimicrobial activity for the Neem treated crosslinking with Glyoxal used of concentration of 6 o.w.f (on the weight of the fabric), and aluminium sulphate ate concentrationof4o.w.faretheoptimumconcentrationsforboththecottonandbamboofabricsused.About30%natural bioactiveagentofneemleavesextractisoptimumconcentrationforgettinggoodantibacterialactivityforboththecotton andbamboofabrics
Table 3: Effect of natural bioactive extracts of Neem (Azadirachta Indica) on cotton and bamboo the bacterial activities
There is a clear in observation table 3 and the figures 2 to zone of inhibition around the fabric finishing with Neem (Azadirachta indica) bioactive agent against both the test organisms in contrast with untreated fabric sample which allowedthegrowthoforganism.Thecontrolcottonandbamboofabricsamplefoundtohavenoantibacterialactivitywith zero area. The methanolic extract of Neem (Azadirachta Indica) agent Against bacteria Bacillus (gram-positive), zone of inhibition increases from 29 to 32 mm on cotton and zone of inhibition increases from 26 to 35 mm on Bamboo with increaseinconcentrationfrom20to30%.Similarly,anincreasefrom24to25mmonCottonandincreasefrom21to24 mmonBamboofabricsamplewasobservedagainstbacteriaE.coli(gram-negative)underthesameconditions.

International Research Journal of Engineering and Technology (IRJET) e-ISSN: 2395-0056
Volume: 11 Issue: 04 | Apr 2024 www.irjet.net p-ISSN: 2395-0072
Bacteria
Control
Bacillus(gram-positive)

E.coli(gram-negative)

2: Evaluation of the Anti-Bacterial Activity of the sample finished with Neem (Azadirachta Indica) on cotton and bamboo
The cellulose fabrics of cotton and bamboo is actively involved in bond formation with the active ingredients of natural bioactiveagentNeemextract.Theactiveingredientsmaybeattachedtocellulosebyphysicalbondingandthecrosslinking agent may act as a bridging material for chemical bond formation with the Neem limonoids. It is also possible that the Neem (Azadirachta indica) extract may be entrapped within the crosslinked molecular chains of the blend fabrics [10] Antimicrobial activity, expressed as growth reduction of the microorganisms, the hydroxyl groups in neem Extract structureinterferewiththebacteria.Theincreasingofconcentrationofneemextractshowsmoretendenciestodepositon the surface of the fibres resulting in hydroxyl groups more easily accessible to microorganisms [11]. Azadirachtin, a complextetranortriterpenoidlimonoidpresentinseeds,isthekeyconstituentresponsibleforbothantifeedantandtoxic

International Research Journal of Engineering and Technology (IRJET) e-ISSN: 2395-0056
Volume: 11 Issue: 04 | Apr 2024 www.irjet.net p-ISSN: 2395-0072
effectsininsects.ResultsthatAlcoholextractofneemleavestoantibacterialactivityagainstbothgramnegativeandgram positivewithgreatestzonesofinhibitionatmaximumconcentration[12].
Thegivenbestresultsofwaterextractare N.W4andmethanolicExtractareN.M4oftheNaturalbioactiveagentisNeem (Azadirachta indica) on cotton and bamboo. Above the tables of 3 and the figures of 2, 3 and4 is conclude that when increase % of concentration, Time and temperature with increased zone inhibition in both Gram positive and Gram NegativeonCottonandBamboofabric.Thegivenabovebestresultsparameterare30%concentration,60minand80 0C.
The ultraviolet protective factor (UPF) is a numerical value which represents the degree of protection against UV rays providedbyclothing.Itisdefinedastheratiooftheamountoftimeneededtoproducedamageonskinprotected witha textile material to the amount of time needed to produce such damage on unprotected skin [13]. The UV blocking properties of textiles can be improved by the integration of metal particles, dyes, pigments or the application of a UVabsorbingfinishtothefabric.UVRadiationisdefinedasthatportionoftheelectromagneticspectrumbetweenxrays and visiblelightTheultravioletradiationbandconsistsofthreeregions:UV-A(320to400nm),UV-B(290to320nm),andUVC (200 to 290 nm). UV-C is totally absorbed by the atmosphere and does not reach the earth. UV-A causes little visible reactionontheskinbuthasbeenshowntodecreasetheimmunologicalresponseofskincells.UV-Bismostresponsiblefor the development of skin cancers. The UV radiation transmission, absorption and reflection are responsible for the UV protectionabilityofafabric[14,15].
Ultra Violet Protection Factor (UPF) is measured on natural Bioactive finishing sample using standard method EN ISO 13758-1:2002 by lab sphere UV-2000F Ultra transmittance analyser. The natural Bioactive agent is used as UV blocking agent because of its non-toxic, chemical and thermal stabilities and durability. Even though they are efficient in the UV region,thereisapossibilityofdeclinemechanicalpropertiesofthetextilematerials. Theresultsareasfollowtables4.
Sr. No.
Observationoftable4itisclearlythatalltreatmentwhichdescribeaboverestrictstheUVBlockingintheregionbetween 260nmto440nminallthefabric.TheUPFisstronglydependentonthechemicalstructureandotheradditivespresentin the fiber. A high correlation exists between the UPF and the fabric porosity but it is also influenced by the type of the fibers.
Table 4 indicate the effect of light exposure on UPF values, percentage UV Blocking for control and methanolic extract natural bioactive agent through finished treated cotton and Bamboo fabric sample. The calculated UPF value of Control cotton fabric 4.2 so, it is not protection against UV-Radiation. The UPF of methanolic extract through finishing Cotton fabricsamplevariesfromtheNeemmethanolicextract N.MhasUPFratingabout30.ThecalculatedUPFvalueofControl bamboofabric24so,itisgoodprotectionagainstUV-Radiation.TheUPFofmethanolicextractthroughfinishingbamboo fabricsamplevariesfromtheNeemmethanolicextractN.MhasUPFratingabout40.
3.4 Structural Analysis
3.4.1 Scanning Electron Microscopy Analysis
A scanning electron microscope HITACHI SU1510 SEM, was used to characterize the surface morphology of the fabric samples. Scanning electron micrographs of untreated fabric and cotton and bamboo treated fabric with the natural bioactive methanolic extract are shown in Tables 5 and 6. It is clear that the dip sample, either treated with the extract

International Research Journal of Engineering and Technology (IRJET) e-ISSN: 2395-0056
Volume: 11 Issue: 04 | Apr 2024 www.irjet.net p-ISSN: 2395-0072
herbsaloneorinpresence ofcrosslinkingagentsamplesarebondedwell tothefabricsurface.Imageoffabric surfaceof varioussampleswastakenonScanningelectronmicroscopeviewsasfollows2mm,1mm,500um.
Surfacemorphologyofvarioussampleswascomparedatsamemicroscopeviewrangeof500umin Tables5and6.SEM image of cotton (C) and bamboo (C) fabric sample indicates the No deposition and it can be observed that the surface of thefabricappearstobesmooth.SEMimageappearanceoftreatedwith Neem(AzadirachtaIndica)methanolicextracthas showndepositiononcottonandBambooFabric.Thesizeofgranulesvaryform0.3umto0.8um.Thiscouldbeadeposit of natural bioactive extract on the surface of fibre. The similarly clear surface is observed in a sample treated with microwave higher Deposition shown at 500 um of Tables 5 and 6 in N.M (F) of the SEM photographs of cotton and bamboofabrictreatedwithpad-dry-curedmethod.Itisclearfromthephotographthatmethanolicextractproducedareof roundribbonshapewithafairlyuniformsizedistribution.Itisclearthatthenaturalbioactiveagentof Neem(Azadirachta Indica) methanolicextractagentarefirmlyfixedonthefibreassemblyofthefabric.










International Research Journal of Engineering and Technology (IRJET) e-ISSN: 2395-0056
Volume: 11 Issue: 04 | Apr 2024 www.irjet.net



TheInfra-Red(IR)spectraofselectedsample(untreatedandtreated)wererecordedonsinglebeamShimadzuFTIR8300 Spectrometer using a resolution of 4 cm. A potassium bromide (KBr) pellet technique was employed. The sample was groundwithKBrfor15mininordertoobtainedfinelydispersedmixture.IRSpectroscopyofvariousTreatmentonCotton andBamboosamples
1. NeemWaterExtract(N.W)
2. NeemMethanolicExtract(N.M)
Was carried out in region of 3500 cm-1 to 500 cm-1 and the spectra are shown in Table 7. It is well known that the IR absorptiongivesinformationaboutatomicvibrationfrequenciesandiscloselyrelatedtotypeofchemicalbondspresent. Cotton contains cellulose, pectin, and waxes. Cellulose and pectins are carbohydrate polymers. Bamboo contains hemicellulose,pectin,lignin,etc.invariouscompositionsalongwithcellulose.
Table 7: FTIR analysis of Treated with Neem (Azadirachta Indica) of Cotton and Bamboo
Sample WaterExtractofNeem(AzadirachtaIndica)

ExtractofNeem(AzadirachtaIndica)


International Research Journal of Engineering and Technology (IRJET) e-ISSN: 2395-0056
Volume: 11 Issue: 04 | Apr 2024 www.irjet.net p-ISSN: 2395-0072


Formaboveobservationtable7 ofchangeinintensityandpositionofvariouspicksindifferentsamplewecansaythatthe change in a pick corresponding to a particular component indicates the change in composition of the particular component. So, compared to untreated fabric the position of picks in conventionally as well as treated sample indicates. ThiswasconfirmedfromtheFTIRspectruminthefrequencyrange3500-500cm-1 asshowninaboveFigureSummarises thegeneralbandassignmentforfibreunderthestudyonthebasicofearlierstudies,whichconfirmedthattheOHgroup wereall HydrogenbondedintheCellulose. Theintensitiesandvalueof IR peaksatdifferentstageindicatethat absence andreductionsofthesecomponentsinthetreatedbamboofibre.
Thestrongabsorptionbandwasseennearat3416.42 cm-1,indicatestretchingof-NHstretchofaminogroups–OHgroup mainly from phenolic groups. The peaks at 2900.69 cm-1 are due to the C-H stretching of alkanes compounds. The absorption peaks near at 2232.94 and 2133.95 cm-1 C≡N stretching of nitriles and –C≡C– stretching of alkynes. The absorptionbandnearerto1643.91cm-1 isindicatesthepresenceof-C=Oand-C=C-stretchrespectivelyofaromaticrings. Theabsorptionbandnearat1430.04cm-1 isC–Hbendofalkanes.TheFT-IRpeak nearat1235cm-1 indicatedaboutC-N stretching. Weak adsorption band nearer to 1,000 cm-1 indicates presence of ether linkages The Bamboo fabric treated with Neem (Azadirachta indica) methanolic extract show the peak of 1736.69 cm-1 C=O stretching of esters, saturated aliphatic.
The essential aim of the present study was the exploration of anti-microbial and UV-Protection properties of Neem (Azadirachtaindica)extractsoncottonandBamboofabric,adventanewtechnologyinconsumerneeds.Thenetresultsof this study were showed that the specimens treated with the extract in presence and absence of crosslinking agent have excellent disinfection properties. The Neem (Azadirachta indica) of Natural bioactive extract finishing of three different Parametersareconcentration,TimeandTemperatureisincreased,whenthecolourstrength(K/SValue)isalsoincreased oncotton and Bamboo. The waterand methanolic extractfinished atparameter of 30%conc., 60 min,and 80 0Cisgives betterresultsthanallothersareobtaineditonbothcottonaswellasBamboomaterial. Thecottonandbamboo,thegiven resultofBacillus(GramPositive)zoneinhibitionisbetterthanthatE.coli(Gramnegative). Itmeansthatbacterialspecies belong to gram positive has high rate of inhibiting growth as compared to the gram negative. The conclude that when increasepercentage(%)ofconcentration,TimeandtemperaturewithincreasedzoneinhibitioninbothGrampositiveand Gram Negative on Cotton and Bamboo fabric. the durability of the treated fabric to antimicrobial property good after 5 washing cyclic. The dyed bamboo fabric treated with Neem ( Azadirachta Indica) methanolic Extract gives protection against UV Radiation in Excellent category. And the dyed cotton fabric treated with Neem methanolic Extract gives protectionagainstUVradiationinverygoodcategory.TheChangestakeplacedatmicrolevelasaresultofconventionalas well as functional finishing processing were analysed through Scanning Electron Microscopy, Infra-red Spectroscopy. Cotton and Bamboo treated with Neem (Azadirachta Indica) were images of microscopic view at 500 um of the SEM photographsconcludethatmethanolicextractproducedareofroundribbonshapewithafairlyuniformsizedistribution. FTIR analysis investigated the presence of mainly compounds in Neem ( Azadirachta Indica) extract which is known to have Antibacterial and UV-protection properties giving on Cotton and Bamboo Material. The natural bioactive agent treatedoncottonandbamboofabricatdifferentparameter.Thestudyofthisresearchweconcludethatincreasedabout 30%concentration,60mintimeand800CtemperatureisgivenbestresultsofAntibacterialandUVprotection.

International Research Journal of Engineering and Technology (IRJET) e-ISSN: 2395-0056
Volume: 11 Issue: 04 | Apr 2024 www.irjet.net p-ISSN: 2395-0072
[1]KokateCK,PurohitAPandGokhaleSB.Pharmacognosy,12thEdn:Pune;NiraliPrakashane1990.p.100-151.
[2]LiuJ.Pharmacologyofoleanolicacidandursolicacid.J.Ethanopharmacology1995;49(2):56-68.
[3] Grover G S and Rao J T. Investigation on the antimicrobial efficiency of essential oils Ocimum sanctum and Ocimum gratissimum.PerfumeandKosmet1979;56:50-52.
[4] Schmutterer H (Ed.). In The Neem Tree-Azadirachta indica A Juss and other Meliaceous Plants: New York; VCH PublishersInc1995.
[5]DevkumarCandSukhdev,inNeem(EdsRandhawaandParmarBS),NeemReaserachandDevelopment2ndEdn:New Delhi,India;SocietyofPesticideScience1996.p.77-96.
[6]Eppler A.TheNeem TreeAzadirachta indica A. Juss andother Meliaceous plants (Ed.)H. Schmuttere:Germany;VCH, Weinheim1995.p.90-107.
[7] Vivek Puri., Pratima Sharma. and Manju Nagpal., “An Update on some Recent Solubility Enhancers as Pharmaceutical Excipients”.JournalofPharmaceuticalTechnology,ResearchandManagement.May-1-2016;Vol-4(1):P-45-62.
[8]BouchekritH.,AazyM.,NasriM.,essentialoilsfromElaeoselinumasclepium:chemicalcomposition,antimicrobial,and antioxidantproperties.AsianPacificJournalofTropicalBiomedicine,(2016)
[9] Chandrasekaran K., Ramachandran T., and Vigneswaran C., “Effect of medicinal herb extracts treated garments on selecteddiseases”.IndianJournalofTraditionalKnowledge.2012;Vol-11(3):P-493-498.
[10] M. Joshi, S. Wazed Ali, S. Rajendran. “Antibacterial Finishing of Polyester/Cotton BlendFabrics Using Neem (Azadirachtaindica):ANaturalBioactiveAgent”.JournalofAppliedPolymerScience.2007;Vol.106:P-793-800.
[11] E.M. El-Khatib, N.F. Ali, R.S.R. El-Mohamedy, “Influence of Neem oil pre-treatment on the dyeing and antimicrobial propertiesofwoolandsilkfiberswithsomenaturaldyes”.ArabianJournalofChemistry.2020;Vol-13:P-1094-1104.
[12]MohammadA.Alzohairy.,“TherapeuticsRoleofAzadirachtaindica(Neem)andTheirActiveConstituentsinDiseases PreventionandTreatment”.1-March-2016;DOI:10.1155/2016/7382506.
[13]Saravanan,D.,“UVProtectiontextilematerial”.AUTEXResearchJournal:2007;Vol-7:P-53–62.
[14]HatchKL,StandardsforUV-protectiontextile,formHighperformanceandfunctionalFinishes,anAATCCSymposium, Charlotte,NC,January2000.
[15] Rieker J, Guschlbauer T and Rusmich S, ‘Wissenschaftliche and praktische Bewertungdes UV-Schutzes’. Melliand Textilberichte,2001,Vol-82(7/8),P-617-619.